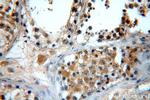
GTPBP5 Antibody in Immunohistochemistry (Paraffin) (IHC (P))
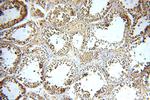
GTPBP5 Antibody in Immunohistochemistry (Paraffin) (IHC (P))

Search
Proteintech
GTPBP5 Polyclonal Antibody
{{$productOrderCtrl.translations['antibody.pdp.commerceCard.promotion.promotions']}}
{{$productOrderCtrl.translations['antibody.pdp.commerceCard.promotion.viewpromo']}}
{{$productOrderCtrl.translations['antibody.pdp.commerceCard.promotion.promocode']}}: {{promo.promoCode}} {{promo.promoTitle}} {{promo.promoDescription}}. {{$productOrderCtrl.translations['antibody.pdp.commerceCard.promotion.learnmore']}}
产品信息
20133-1-AP
种属反应
宿主/亚型
分类
类型
抗原
偶联物
形式
浓度
规格
纯化类型
保存液
内含物
保存条件
运输条件
产品详细信息
Immunogen sequence: LPGKKLLSE KKLKRYFVDY RRVLVCGGNG GAGASCFHSE PRKEFGGPDG GDGGNGGHVI LRVDQQVKSL SSVLSRYQGF SGEDGGSKNC FGRSGAVLYI RVPVGTLVKE GGRVVADLSC VGDEYIAALG GAGGKGNRFF LANNNRAPVT CTPGQPGQQR VLHLELKTVA HAGMVGFPNA GKSSLLRAIS NARPAVASYP FTTLKPHVGI VHYEGHLQIA VADIPGIIRG AHQNRGLGSA FLRHIERCRF LLFVVDLSQP EPWTQVDDLK YELEMYEKGL SARPHAIVAN KIDLPEAQAN LSQLRDHLGQ EVIVLSALTG ENLEQLLLHL KVLYDAYAEA ELGQGRQPLR W (57-406 aa encoded by BC036716)
靶标信息
Small G proteins, such as GTPBP5, act as molecular switches that play crucial roles in the regulation of fundamental cellular processes such as protein synthesis, nuclear transport, membrane trafficking, and signal transduction (Hirano et al., 2006 ).
仅用于科研。不用于诊断过程。未经明确授权不得转售。
生物信息学
蛋白别名: GTP binding protein 5; GTP binding protein 5 (putative); GTP-binding protein 5; Mitochondrial ribosome-associated GTPase 2; ObgH1; Protein obg homolog 1; unnamed protein product
基因别名: 1810011P19Rik; 2900056P18Rik; D2Bwg0647e; dJ1005F21.2; GTPBP5; MTG2; OBGH1
UniProt ID: (Human) Q9H4K7
Entrez Gene ID: (Human) 26164, (Mouse) 52856, (Rat) 296462